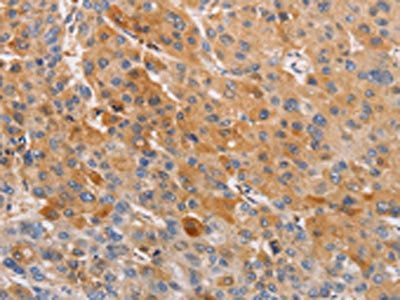
OLR1 Antibody

You have no items in your shopping cart.
Description
Research Area
Images & Validation
−| Application Notes |
|---|
Key Properties
−| Source | E.coli |
|---|---|
| Biological Origin | Homo sapiens (Human) |
| Tag | N-terminal 6xHis-tagged |
| Molecular Weight | 28.7 kDa |
| Expression Region | 58-273aa |
| Protein Length | Extracellular Domain |
| Protein Sequence | MQLSQVSDLLTQEQANLTHQKKKLEGQISARQQAEEASQESENELKEMIETLARKLNEKSKEQMELHHQNLNLQETLKRVANCSAPCPQDWIWHGENCYLFSSGSFNWEKSQEKCLSLDAKLLKINSTADLDFIQQAISYSSFPFWMGLSRRNPSYPWLWEDGSPLMPHLFRVRGAVSQTYPSGTCAYIQRGAVYAENCILAAFSICQKKANLRAQ |
| Purity | Greater than 90% as determined by SDS-PAGE. |
Storage & Handling
−| Storage | The shelf life is related to many factors, storage state, buffer ingredients, storage temperature and the stability of the protein itself. Generally, the shelf life of liquid form is 6 months at -20℃/-80℃. The shelf life of lyophilized form is 12 months at -20℃/-80℃. |
|---|---|
| Form/Appearance | Liquid or Lyophilized powder |
| Buffer/Preservatives | If the delivery form is liquid, the default storage buffer is Tris/PBS-based buffer, 5%-50% glycerol. If the delivery form is lyophilized powder, the buffer before lyophilization is Tris/PBS-based buffer, 6% Trehalose, pH 8.0. |
| Expiration Date | 6 months from date of receipt. |
| Disclaimer | For research use only |
Alternative Names
−Similar Products
−Recombinant Human OLR1 Protein [orb2995018]
Unconjugated
SDS-PAGE: Greater than 95% as determined by reducing SDS-PAGE.
Predicted: 25.39 KDa. Observed: 30-35 KDa, reducing conditions
10 μg, 50 μg, 500 μg, 1 mgOLR1 Rabbit Polyclonal Antibody [orb381928]
IHC, WB
Human
Rabbit
Polyclonal
Unconjugated
50 μl, 100 μl, 200 μl, 30 μl

Quality Guarantee
Explore bioreagents carefree to elevate your research. All our products are rigorously tested for performance. If a product does not perform as described on its datasheet, our scientific support team will provide expert troubleshooting, a prompt replacement, or a refund. For full details, please see our Terms & Conditions and Buying Guide. Contact us at [email protected].

(Tris-Glycine gel) Discontinuous SDS-PAGE (reduced) with 5% enrichment gel and 15% separation gel.
Quick Database Links
UniProt Details
−Documents Download
Request a Document
Protocol Information
Human LOX-1 protein (orb382965)
Participating in our Biorbyt product reviews program enables you to support fellow scientists by sharing your firsthand experience with our products.
Login to Submit a Review